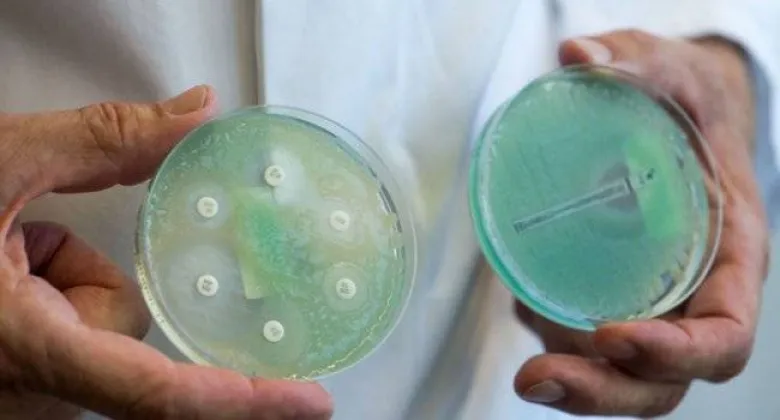

Ամերիկացիները հայտարարել են սուպեր հակաբիոտիկ ստեղծելու մասին
Ամերիկացի գիտնականները վանկոմիցին հակաբիոտիկի տարատեսակ են ստեղծել, որն ունակ է պայքարել սուպերբակտերիաների դեմ. օրգանիզմների, որոնք չեն ենթարկվում բուժման ավանդական մեթոդներին: Համապատասխան հետազոտությունը հրապարակվել է Proceedings of the National Academy of Sciences ամսագրում:
Գիտնականները նշում են, որ այդ հակաբիոտիկը բժիշկները նշանակում են արդեն 60 տարի, բայց բակտերիաները նրա նկատմամբ դիմակայելու ունակություն ձեռք են բերել միայն հիմա: Այն քանդում է բակտերիաների բջիջների պատերը, փոխում է բակտերիայի բջջային մեմբրանի թափանցելիությունն ու ՌՆԹ-ի սինթեզը: Վանկոմիցինի նոր տարբերակը մանրէի վրա ազդում է երեք անկախ մեխանիզմներով, ինչի պատճառով բակտերիաները չեն հասցնում պաշտպանվել նրանից: Եթե անգամ նրանք կարողանան պաշտպանություն ստեղծել նման մեխանիզմներից մեկի համար, միեւնույն է, կոչնչանան մյուս երկուսի գործունեությունից, ասում է Սքրիփսի գիտահետազոտական ինստիտուտի (TSRI) քիմիկոս Դեյլ Բոուջերը: Նրա խոսքով՝ մոդիֆիկացված դեղորայքի նույն չափաբաժինն ավելի մեծ ազդեցություն է ունենում, քան նախկինը:
Գիտնականներն արդեն դեղամիջոցը փորձարկել են էնտերոկոկերի վրա, ընդ որում՝ վանկոմիցինի նոր տարբերակը ոչնչացրել է անգամ այն բակտերիաները, որոնք դիմակայություն էին դրսեւորում հակաբիոտիկների նկատմամբ: Հետագայում գիտնականները մտադիր են օպտիմալացնել վանկոմիցինի ստացման պրոցեսը, քանի որ ներկայում դեղամիջոցի սինթեզը 30 փուլ է անցնում: Բայց սա խնդրի դյուրին մասն է՝ մոլեկուլի նախագծման առաջնահերթ խնդրի հետ համեմատ, ասում է Բոուջերը:
Հակաբիոտիկի այս կատարելագործված «տարբերակի» հիմնական խնդիրը դեռեւս մնում է նրա արտադրության բարդությունը. այն ներառում է 30 տարբեր փուլ եւ բավական բարդ ռեակցիաներ: Այնպես որ՝ մասնագետներն ապագայում պետք է մոդիֆիկացված վանկոմիցինի սինթեզման ավելի արդյունավետ միջոց մշակեն:

Հրապարակվել է հազար խոշոր հարկատուների ցանկը. վճարված գումարները կազմել են ավելի քան 1 տրլն 946 մլրդ...
Շինարարական ընկերություններին ներկայացվող պահանջները խստացվել են
Համատեղ ջանքերի շնորհիվ մեզ կհաջողվի նոր մակարդակի բարձրացնել երկկողմ քաղաքական երկխոսությունը․ Փաշի...
Մահացել է Երևանի նախկին քաղաքապետ Ռոբերտ Նազարյանը
Բոլորը պետք է փոխզիջման գնան, ի դեպ` նաեւ ամերիկյան, Վիլնյուսում ասել է Զելենսկին
Հունվարի 27-ը Հայրենիքի պաշտպանության համար զոհվածների հիշատակի օրն է
ԱՄՆ-ում առատ ձյան տեղումների և սառույցի պատճառով 24 նահանգներում արտակարգ դրություն է հայտարարվել
Ժամանակավորապես կդադարեցվի հետևյալ հասցեների էլեկտրամատակարարումը
Փոսը շրջանցելու համար, վարորդները երթևեկում են հանդիպակաց գոտիով՝ վթարային իրավիճակնեը ստեղծելով մյո...
17-ամյա Աննա Զաքարյանը որոնվում է որպես անհետ կորած